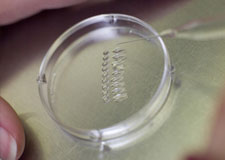
Gam

Gametes/Embryos
ART Donation (Egg, Sperm & Embryo)
ART Donation (Egg, Sperm & Embryo)
Egg Donation is the process by which a woman provides one or several eggs (ova) for purposes of assisted reproduction through in vitro fertilization (IVF), whereby the eggs are fertilized in the laboratory and then implanted into another woman’s uterus. Donors may be anonymous or identified. The Federal Drug Administration (FDA) and the American Society of Reproductive Medicine (ASRM) have issued guidelines for these procedures. Attorneys experienced in egg donation represent intended parents or egg donors in drafting or reviewing donor agreements. This is particularly important with identified donors, because the laws in many states do not protect the parties or the children in these situations, unless specific language and legal citations are used in the agreements. For more information about hiring an attorney, click on AAARTA Fellows. To find an AAARTA attorney in your state, click on Online Member Directory.
Sperm Donation
Sperm Donation is the process by which a man donates his sperm with the intention that it be used to impregnate a woman who is not usually the man’s sexual partner in order to produce a child through IVF or artificial insemination. A man may donate sperm as an anonymous or identified donor through a sperm bank or a fertility clinic. A sperm donor may also donate directly to the recipient. Sperm donation is used to assist heterosexual couples unable to produce children because of “male factor” fertility problems and is now also available to enable single women and partnered lesbians to conceive children. The FDA has regulations governing the use of donor sperm in medical and fertility clinics. Attorneys experienced in gamete donation represent intended parents or sperm donors in drafting or reviewing donor agreements. This is particularly important with identified donors, because the laws in many states do not protect the parties or the children in these situations, unless specific language and legal citations are used in the agreements. For more information about hiring an attorney, click on AAARTA Fellows. To find an AAARTA attorney in your state, click on Online Member Directory.
